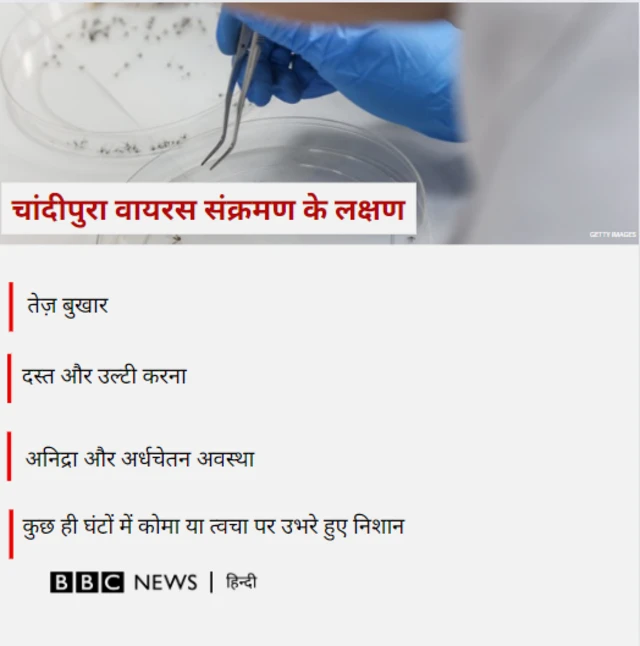
वायरस के लक्षण

बच्चों में फैलने वाला चांदीपुरा वायरस क्या है? इससे कैसे बचें

इमेज स्रोत, Getty Images
- Author, लक्ष्मी पटेल
- पदनाम, बीबीसी गुजराती संवाददाता
- पढ़ने का समय: 9 मिनट
गुजरात में पिछले दो हफ्तों में चांदीपुरा वायरस से छह बच्चों की मौत होने का दावा किया जा रहा है.
हालाँकि, क्या इन बच्चों की मौत चांदीपुरा वायरस के कारण हुई है? इसका पता लगाने के लिए गुजरात सरकार ने बच्चों के ख़ून के नमूने जांच के लिए पुणे के नेशनल इंस्टीट्यूट ऑफ़ वायरोलॉजी में भेजा हैं.
मच्छर जनित इस बीमारी का शिकार होने वाले बच्चे की 24 से 48 घंटे के अंदर मौत हो जाती है.
डॉक्टरों के मुताबिक़, इस बीमारी से पीड़ित बच्चों में मृत्यु दर 85 प्रतिशत है. ये बीमारी की गंभीरता को दर्शाता है.
मॉनसून के दौरान वायुमंडल में नमी के चलते मक्खियों, मच्छरों और कीड़ों का प्रकोप अपेक्षाकृत बढ़ जाता है. अतः संक्रामक रोग तुरंत फैल जाते हैं.
चांदीपुरा वायरस ऐसी संक्रामक बीमारी है जो सेंड फ़्लाइज़ के काटने से फैलता है.
गुजरात के अरावली और साबरकांठा ज़िलों में पाए गए प्रभावित बच्चों के लक्षणों से डॉक्टरों को लगने लगा है कि उनकी मौत चांदीपुरा वायरस के कारण हुई होगी.

चांदीपुरा वायरस क्या है, यह कैसे फैलता है

इमेज स्रोत, ANKIT CHAUHAN
इस बीच, गुजरात में मृत बच्चों के माता-पिता को इस बीमारी के बारे में पता नहीं था. लेकिन बच्चों की तबीयत बिगड़ने पर वे उन्हें इलाज के लिए अस्पताल ले गए.
हालांकि आख़िर में कुछ बच्चों की जान बचा नहीं सकी.
हिम्मतनगर सिविल अस्पताल के शिशु रोग विशेषज्ञ डॉक्टर आशीष जैन ने इन बच्चों में चांदीपुरा वायरस होने की आशंका जताई है.
आशीष जैन ने कहा, "कुछ माता-पिता अपने बच्चों को हमारे अस्पताल में लाए. उन्हें बताया गया कि उन्हें तेज़ बुख़ार, दस्त, उल्टी है. 24 घंटे के भीतर, बच्चे को मस्तिष्क का दौरा पड़ा और गुर्दे और हृदय पर तेजी से असर पड़ा. इसलिए हमने बीमारी का निदान किया. जापानी एन्सेफलाइटिस या चांदीपुरा के रूप में हमें लगता है कि यह एक वायरस हो सकता है."
उन्होंने कहा कि पिछले साल हमारे पास चांदीपुरा वायरस का एक पॉजिटिव केस आया था. बरसात का मौसम भी है. इस मौसम में चांदीपुरा संक्रमण के मामले देखे जाते हैं.
जून के अंत से अक्टूबर तक मामले घटित होने की अधिक संभावना है. इसलिए हमने बच्चों के रक्त के नमूने पुणे की एक प्रयोगशाला में भेजे हैं. जैन ने बताया कि नतीजे मंगलवार या बुधवार (23-24 जुलाई) तक आने की उम्मीद है.
महाराष्ट्र स्वास्थ्य विभाग के मुताबिक, चांदीपुरा एन्सेफलाइटिस एक वायरस है.
इसका पता पहली बार 1965 में नागपुर क्षेत्र के चंडीपुरा इलाके में मरीजों के रक्त सैंपल की जांच में लगाया गया था. इसलिए इसका नाम चांदीपुरा पड़ा.
चांदीपुरा वायरस रेत मक्खी के काटने से फैलता है.
सैंड फ्लाई मच्छर से छोटी मक्खी होती है और इसका रंग रेत जैसा होता है. मक्खी के पंख बालों वाले होते हैं.
मक्खी का आकार 1.5 से 2.5 मिलीमीटर होता है. भारत में रेत मक्खियों की कुल 30 प्रजातियाँ पाई जाती हैं.
सैंडफ़्लाइज़ रात में सबसे अधिक सक्रिय होती हैं और उनके काटने से बहुत दर्द होता है.
वे नग्न आंखों से मुश्किल से ही दिखाई देते हैं. दिन के दौरान, रेत की मक्खियाँ अंधे स्थानों, दीवारों की दरारों और दरारों में रहती हैं.
ये मक्खियाँ रात में सक्रिय होती हैं और घर में लोगों को काटती हैं. मादा मक्खी को अंडे देने के लिए हर 3 या 4 दिन में रक्त की आवश्यकता होती है.
स्वास्थ्य विभाग के मुताबिक़, ये बीमारी मुख्य रूप से ग्रामीण और आदिवासी इलाकों में पाई जाती है. लेकिन वर्तमान में शहरी क्षेत्रों की झुग्गी बस्तियों में भी मरीज़ो की संख्या अधिक पाई जा रही है.
स्वास्थ्य से जुड़ी अन्य ख़बरें यहां पढ़ेंः-
यह रोग कैसे होता है और क्या यह संक्रामक है

इमेज स्रोत, DAXESH SHAH
इस बीमारी के फैलने के बारे में डॉक्टर आशीष जैन ने बताया, "चांदीपुरा वायरस आमतौर पर सैंड फ़्लाइज़ और कभी-कभी मच्छरों द्वारा फैलता है."
ये मक्खियाँ घरों की दीवार, दरवाज़ों में खाली जगह या मिट्टी के घरों की दरारों में पाई जाती हैं.
"सैंड फ़्लाइज़ का संक्रमण सीमेंट की छत वाले घरों की दरारों में भी पाया जा सकता है. यदि आसपास कीचड़ और धूल है, तो कम रोशनी वाले या कम धूप वाले अंधेरे कमरों में भी सैंड फ़्लाइज़़ का प्रजनन हो सकता है."
उन्होंने यह भी बताया, "यह कोई महामारी वाली बीमारी नहीं है. अगर एक बच्चे को यह हो जाए तो यह दूसरे बच्चे को संक्रमित नहीं करती है, लेकिन अगर किसी संक्रमित बच्चे को काटने वाली मक्खी किसी स्वस्थ बच्चे को काट ले तो वह स्वस्थ बच्चा भी संक्रमित हो सकता है. फ़िलहाल, वहीं किसी खास गांव या इलाके में ज़्यादा मामले आ रहे हैं. अलग-अलग जगहों से मामले आ रहे हैं."
बीमारी की गंभीरता के बारे में बात करते हुए आशीष जैन ने कहा, "इस बीमारी से प्रभावित बच्चों में मृत्यु दर लगभग 85 प्रतिशत है. इसका मतलब है कि चांदीपुरा वायरस की चपेट में आने वाले 100 बच्चों में से केवल 15 को ही बचाया जा सकता है."
नौ साल से 14 साल की आयु के बच्चे जो मिट्टी के घरों या गंदे इलाकों में रहते हैं, उनमें दूसरों की तुलना में प्रतिरोधी क्षमता कम होती है, जिससे वे बीमारी से लड़ने में कम सक्षम होते हैं.
इस बीमारी का इलाज क्या है?

इमेज स्रोत, ANKIT CHAUHAN
डॉक्टरों के मुताबिक़, इस वायरस का फ़िलहाल कोई ख़ास इलाज नहीं है.
इस वायरस का इलाज लक्षणों के आधार पर होता है. इस बीमारी का अभी तक कोई टीका नहीं खोजा जा सका है.
हिम्मतनगर सिविल अस्पताल अधीक्षक डॉक्टर परेश शिलादरिया ने बीबीसी गुजराती से बात करते हुए कहा, "पहला संदिग्ध वायरस वाला बच्चा 27 जून को हमारे अस्पताल में आया था. बच्चे में फ्लू जैसे लक्षण थे. साथ ही, बच्चे की मलेरिया रिपोर्ट भी नेगेटिव आई थी. हमारे बाल रोग विशेषज्ञ को संदेह था कि वह चांदीपुर वायरस से संक्रमित हो सकता है."
इसलिए, बच्चों के रक्त के नमूने पुणे की एक प्रयोगशाला में भेजे गए हैं.
अरावली जिला मुख्य स्वास्थ्य अधिकारी एमके सिद्दीकी ने बीबीसी गुजराती को बताया, "अरावली ज़िले में पहला मामला 3 जुलाई को सामने आया था, जबकि भिलोडा तालुका के एक लड़के को बुख़ार के साथ सरकारी स्वास्थ्य केंद्र (सीएचसी) लाया गया था."
"वहां, बच्चे को अचानक दौरा पड़ा. उपस्थित डॉक्टर ने तुरंत बच्चे को हिम्मतनगर सिविल अस्पताल में ले गए. वहां, 5 जुलाई को 48 घंटों के भीतर बच्चे की मृत्यु हो गई."
उन्होंने यह भी बताया कि अब तक हमारे यहां कुल दो बच्चों की मौत हुई है, एक भिलोडा तालुका में और एक अरावली ज़िले के मेघराज तालुका में.
उन्होंने इस बीमारी से बचाव के उपायों पर कहा, "हम इस बीमारी की रोकथाम के लिए उपाय कर रहे हैं. प्रत्येक प्राथमिक स्वास्थ्य केंद्र द्वारा गांव के बच्चों की जांच की जा रही है. कीटाणुनाशक और छिड़काव भी किया जा रहा है."
क्या सावधानियाँ बरतनी चाहिए
- घर और आसपास साफ-सफाई रखनी चाहिए. मच्छरदानी में सोएं.
- ध्यान रखें कि आस पास पानी जमा न हो.
- मच्छर और मक्खी के उपद्रव से बचने के लिए सावधानी बरतनी चाहिए.
- सैंडफ्लाई मक्खी इस रोग की वाहक है और यह उत्पत्ति स्थान से अधिक दूर तक नहीं जा सकती इसलिए इसे नियंत्रित करना आसान है.
- यदि गांव में घर हो तो पशुशाला एवं अन्य अंधेरे स्थानों पर कीटनाशक का छिड़काव करना चाहिए.
- आवासीय क्षेत्र में अच्छी साफ-सफाई कराई जाए.
- घर की दीवारों की दरारों को सील कर दें और पालतू पशुओं के बाड़े और मुर्गों के मल को रहने वाले घर से दूर रखें.
गुजरात सरकार ने क्या कहा?

इमेज स्रोत, ANKIT CHAUHAN
स्वास्थ्य मंत्री ऋषिकेश पटेल ने मीडिया को इस बीमारी के बारे में जानकारी देते हुए कहा कि 'चांदीपुरा वायरल इंसेफेलाइटिस से घबराने की ज़रूरत नहीं है, लेकिन सावधानी बरतनी होगी. यह कोई नई बीमारी नहीं है.'
उन्होंने कहा, "1965 में महाराष्ट्र में ज्वर के लक्षणों के साथ मस्तिष्क ज्वर (सीएचपीवी) की महामारी सामने आई थी. बाद में आंध्र प्रदेश और गुजरात सहित अन्य राज्यों में भी इसकी सूचना मिली."
यह वायरस वेसिकुलोवायरस परिवार का है. गुजरात में हर साल इस बीमारी के मामले सामने आते हैं. यह बीमारी विशेष रूप से उत्तर-मध्य गुजरात के जिलों में, मॉनसून के दौरान और विशेषकर ग्रामीण क्षेत्रों में आम है.
उन्होंने कहा, "राज्य में अब तक चांदीपुरा वायरस के 12 संदिग्ध मामले पाए गए हैं. उनमें से छह की मौत हो चुकी है. इसके अलावा छह मरीज़ों का अभी इलाज चल रहा है. साबरकांठा में चार, अरावली में तीन, महिसागर और खेड़ा ज़िले में एक-एक संदिग्ध मरीज़ मिला है."
"राजस्थान के दो और मध्य प्रदेश के एक रोगी गुजरात में इलाज चल रहा है. वैसे सैंपल के नतीजे आने के बाद ही पता चलेगा कि यह चांदीपुरा वायरस की बीमारी का मामला था या नहीं."


















